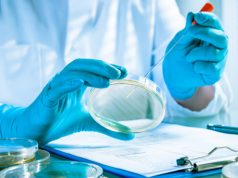
Що потрібно знати про лістеріоз! Що-потрібно-знати-про-лістеріоз!

В Івано-Франківській області сотня людей перекрила дорогу і напала на двох жінок та дитину....
У Косівському районі Івано-Франківської області близько 100 людей перекрили дорогу та завдали травм двом жінкам та дитині.
Переглянути ВІДЕО: https://censor.net/ua/photo_news/3472176/v_ivanofrankivskiyi_oblasti_sotnya_lyudeyi_perekryla_dorogu_i_napala_na_dvoh_jinok_ta_dytynu_odnu_z
Ваш браузер не підтримує HTML5-відео
Прикордонники влучними скидами гранат ліквідували двох окупантів, ще трьох – поранили. ВIДЕО
Влучними скидами гранат прикордонники бригади Гвардії наступу "Помста" ліквідували двох окупантів на Бахмутському напрямку. Ще трьох загарбників – поранили.
Переглянути ВІДЕО: https://censor.net/ua/video_news/3472167/prykordonnyky_vluchnymy_skydamy_granat_likviduvaly_dvoh_okupantiv_sche_troh_poranyly_video
Ваш браузер не підтримує...
У Нововолинському центрі зайнятості провели тренінг для учасників бойових дій та осіб з інвалідністю...
Джерело: Нововолинська міська рада
7 лютого у приміщенні Нововолинського управління Володимир-Волинської філії Волинського обласного центру зайнятості відбувся інформаційний семінар для учасників бойових дій та...
“Навала вологих серветок” тероризує місто!?
Міська каналізація не встигає передихати від навали вологих серветок, - йдеться в повідомленні КП Нововолинськводоканал у Фейсбук.
"Міська каналізація не встигає передихати від навали вологих...
Що потрібно знати про лістеріоз!
Джерело: Нововолинська міська рада
Перші згадки про цю хворобу датуються ще 1892 роком. Але сьогоднішню офіційну назву бактерії отримали в 1927 році, коли мікробіолог...
Окупанти збирають у чорні пакети рештки своїх “двохсотих”. ВIДЕО
У мережі опублікований відеозапис результату удару українських воїнів по базі окупантів на донецькому напрямку.
Переглянути ВІДЕО: https://censor.net/ua/video_news/3472119/okupanty_zbyrayut_u_chorni_pakety_reshtky_svoyih_dvohsotyh_video
Ваш браузер не підтримує HTML5-відео
Чоловік вчетверте за місяць намагався незаконно перетнути кордон. Його знов затримали. ВIДЕО
44-річний мешканець Харкова вчетверте за місяць спробував нелегально потрапити за межі України. За маршрут заплатив $3,5 тис., але це не допомогло.
Переглянути ВІДЕО: https://censor.net/ua/video_news/3472111/cholovik_vchetverte_za_misyats_namagavsya_nezakonno_peretnuty_kordon_yiogo_znov_zatrymaly_video
Ваш браузер...
Бійці підрозділу “Команчі” із 40-ї ОАБр знищили FPV-дронами “Дикі Шершні” 21 артустановку за місяць....
Бійці підрозділу "Команчі" із 40-ї ОАБр знищили FPV-дронами "Дикі Шершні" за один місяць 21 ворожу установку за місяць.
Переглянути ВІДЕО: https://censor.net/ua/video_news/3472107/biyitsi_pidrozdilu_komanchi_iz_40yi_oabr_znyschyly_fpvdronamy_dyki_shershni_21_artustanovku_za_misyats
Ваш браузер не підтримує HTML5-відео
У Благодатному попрощалися із Захисником України Віктором Каліновським
Джерело: Нововолинська міська рада
7 лютого Нововолинська громада прощалася із Захисником України, мешканцем Благодатного Віктором Каліновським.Коли в Україну прийшла війна, Віктор став до лав Захисників,...
Суд розглядає клопотання про продовження тримання Червінського під вартою. ВІДЕО+ФОТОрепортаж
Шевченківський райсуд Києва продовжує розгляд клопотання про продовження тримання під вартою полковника Романа Червінського.
Переглянути ВІДЕО: https://censor.net/ua/photo_news/3472063/sud_rozglyadaye_klopotannya_pro_prodovjennya_trymannya_chervinskogo_pid_vartoyu_videofotoreportaj
Ваш браузер не підтримує HTML5-відео
Артилеристи поцілили в інженерну техніку окупантів: “Экскаваторщик – “двести”, тракторист – “триста”. Шариками у#бало”....
Українські воїни поцілили в екскаватор та трактор, які працювали на зведенні ворожих оборонних споруд на окупованих територіях.
Переглянути ВІДЕО: https://censor.net/ua/video_news/3472049/artylerysty_potsilyly_v_injenernu_tehniku_okupantiv_kskavatorschyk_dvesty_traktoryst_trysta_sharykamy
Ваш браузер не підтримує HTML5-відео
Бійці за допомогою шведського ПТРК NLAW знищують дві ворожі бронемашини. ВIДЕО
На Запоріжжі українські воїни уразили дві ворожі бронемашини за допомогою шведського ПТРК NLAW.
Переглянути ВІДЕО: https://censor.net/ua/video_news/3472044/biyitsi_za_dopomogoyu_shvedskogo_ptrk_nlaw_znyschuyut_dvi_voroji_bronemashyny_video
Ваш браузер не підтримує HTML5-відео
Майже 30 тисяч осіб звернулися у Нововолинський ЦНАП за адмінпослугами у 2023 році
Джерело: Нововолинська міська рада
Під час засідання виконавчого комітету, що відбулося 7 лютого, начальниця управління Центр надання адміністративних послуг Алла Ковальчук відзвітувала про роботу...
Відбулося чергове засідання виконавчого комітету
Джерело: Нововолинська міська рада
У середу, 7 лютого, заступник міського голови Микола Пасевич провів засідання виконавчого комітету міської ради. Розглянули майже 50 питань порядку...
На Львівщині є влучання: Росіяни атакували промисловий об’єкт у Дрогобичі. ВIДЕО
Російські окупанти вранці атакували Львівщину. Зафіксовано влучання у промисловий об’єкт в Дрогобичі.
Переглянути ВІДЕО: https://censor.net/ua/news/3472003/na_lvivschyni_ye_vluchannya_rosiyany_atakuvaly_promyslovyyi_obyekt_u_drogobychi_video
Ваш браузер не підтримує HTML5-відео
Нейтралізовано агентурну мережу ФСБ РФ: затримано 5 учасників, серед яких колишні та нинішні посадовці...
Служба безпеки нейтралізувала агентурну мережу військової контррозвідки ФСБ, яка діяла в Україні. У результаті багатоетапної спецоперації у різних регіонах затримано 5 учасників ворожої групи....
Дрон-камікадзе поцілив окупанту нижче спини. ВIДЕО
Оператор дрона-камікадзе із 63-ї ОМБр ліквідував окупанта, поціливши йому безпілотником у зад.
Переглянути ВІДЕО: https://censor.net/ua/video_news/3471781/dronkamikadze_potsilyv_okupantu_nyjche_spyny_video
Ваш браузер не підтримує HTML5-відео
Голова ОП Єрмак, ймовірно, замовив стеження за журналістами, – Бігус. ВIДЕО
У новому відео проєкту розслідувань Bihus.Info йдеться про те, що операція з прослуховування та відеозйомки їхніх колишніх колег велася за наказом одного з департаментів...
Окупант перед смертю намагається з автомата збити український дрон-камікадзе. ВIДЕО
Українські FPV-дрони під пілотуванням бійців 110-ої окремої механізованої бригади ліквідували російського загарбника.
Переглянути ВІДЕО: https://censor.net/ua/video_news/3471938/okupant_pered_smertyu_namagayetsya_z_avtomata_zbyty_ukrayinskyyi_dronkamikadze_video
Ваш браузер не підтримує HTML5-відео
Щойно підписав указ, який розпочинає створення у наших Силах оборони окремого роду сил –...
У своєму щоденному зверненні Володимир Зеленський розповів про свій указ щодо створення в структурі ЗСУ Сил безпілотних систем.
Переглянути ВІДЕО: https://censor.net/ua/video_news/3471934/schoyino_pidpysav_ukaz_yakyyi_rozpochynaye_stvorennya_u_nashyh_sylah_oborony_okremogo_rodu_syl_syl_bezpilotnyh
Ваш браузер не підтримує HTML5-відео